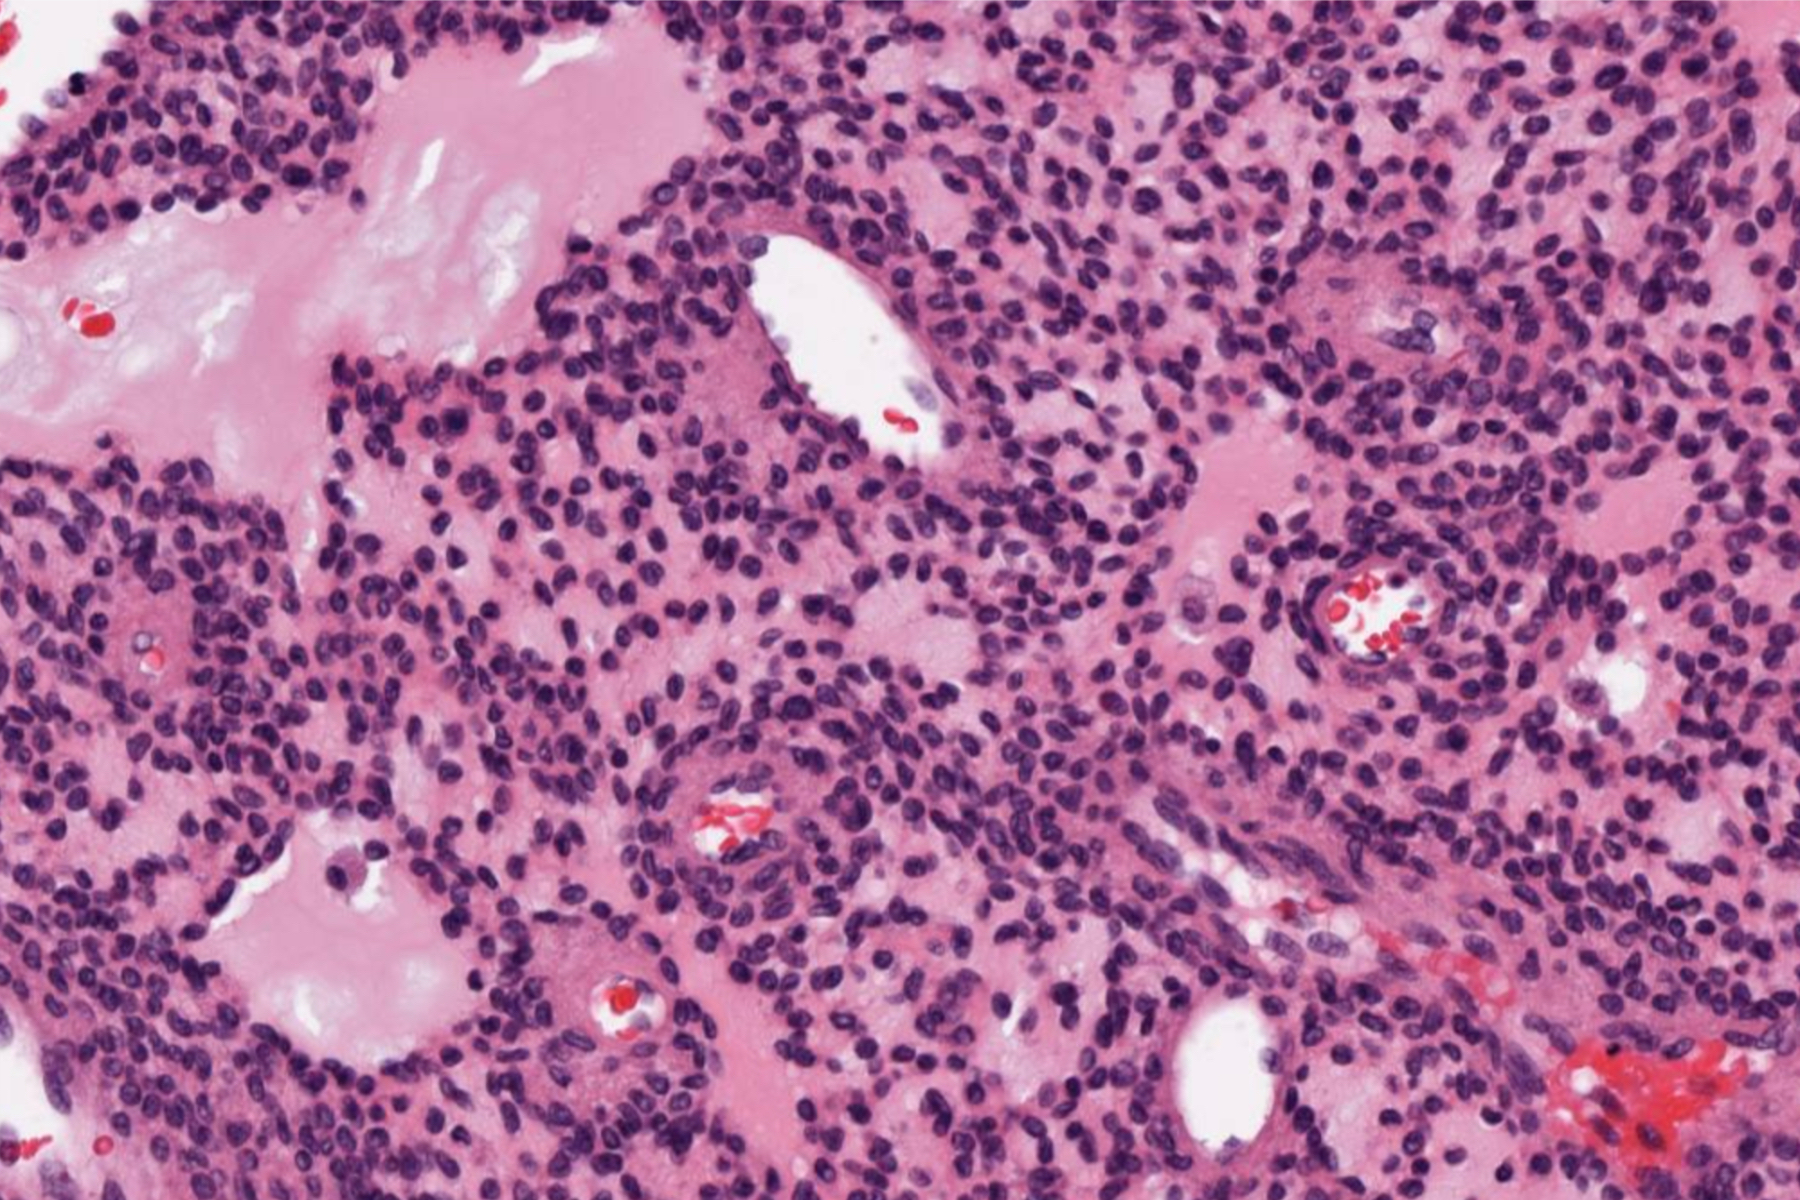

软组织磷酸盐尿性间叶性肿瘤
Phosphaturic mesenchymal tumor
概述:
软组织及骨的间充质肿瘤,以肿瘤介导骨软化为特征
发病部位: 四肢,以大腿和足多见,鼻窦等软组织和骨
诊断要点:
- 常见于中年,偶可见于婴幼儿;
- 以四肢、鼻窦等部位的软组织及骨多见,一般体积较小,常包含脂肪,部分病例显著钙化;
- 肿瘤细胞梭形及星状,疏松状排列,可产生特征性的“污浊”或絮状基质,常伴有钙化;
- 间质血管丰富,可呈血管外皮瘤样,由分化良好的分支毛细血管构成,有时呈海绵状血管瘤样;
- 常见破骨细胞样巨细胞。

免疫组织化学染色:
FGF-23 阳性,缺乏其他细胞特异性分化抗原。
鉴别诊断:
孤立性纤维性肿瘤:缺乏特征性的钙化基质。
软组织软骨瘤: 缺乏梭形细胞和脂肪成分
← 骨黑色素性神经外胚层瘤 骨孤立性纤维性肿瘤 →
